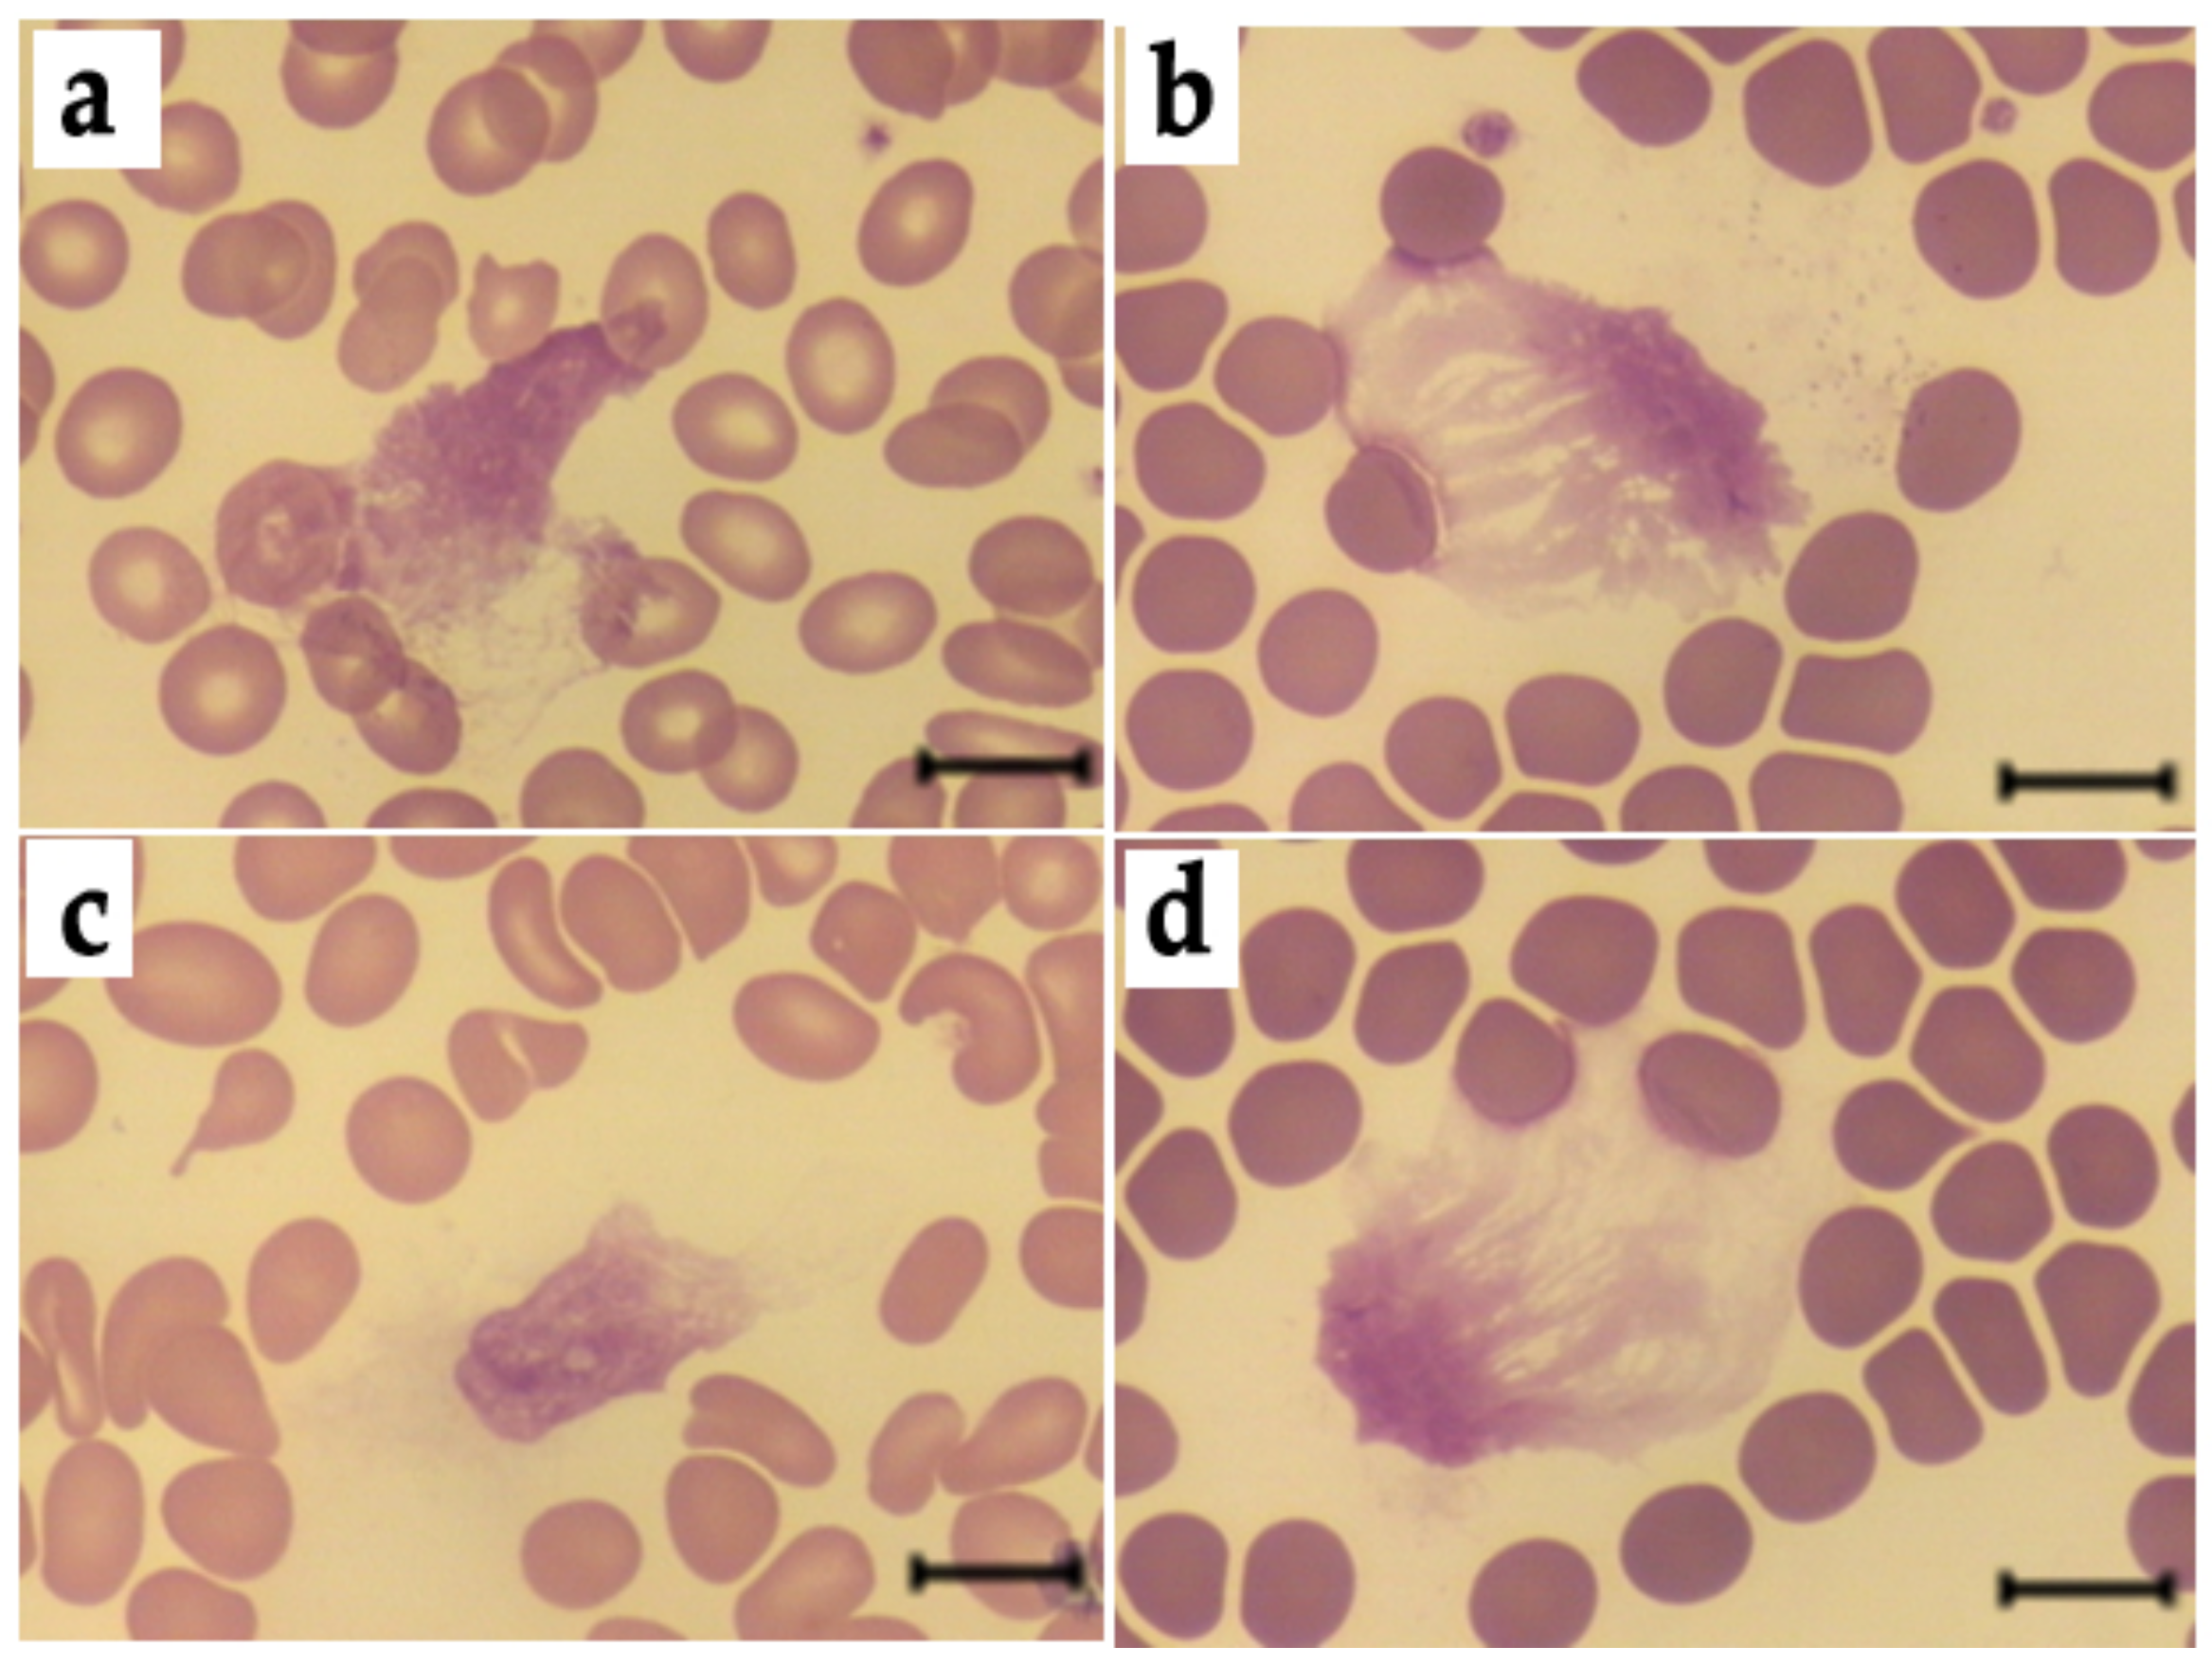
Antioxidants 11 02263 g011

Methylglyoxal-Modified Human Serum Albumin Binds to Leukocyte Myeloperoxidase and Inhibits its Enzymatic Activity
Abstract
:1. Introduction
2. Materials and Methods
2.1. Reagents Used
2.2. Modification of HSA
2.3. MPO Isolation
2.4. Anti-MPO Monoclonal Antibodies
2.5. Neutrophil Isolation
2.6. Affinity Chromatography of HSA-MG on MPO–Sepharose
2.7. Detection of MPO and HSA-MG Interaction Using Disc-Electrophoresis without Detergent and Ligand Western Blotting Assay
2.8. Detection of MPO and HSA-MG Interaction by ELISA
2.9. Evaluation of Dissociation Constant (Kd) Value of MPO-HSA-MG Complex and MPO-Binding Capacity Assay
2.10. MPO Enzymatic Activity
2.11. Neutrophil Chemiluminescence
2.12. Assays for Degranulation of Human Neutrophils
2.13. Spontaneous and PMA-Stimulated NETosis
2.14. Statistical Analysis
3. Results
3.1. Characteristics of HSA-MG
3.2. HSA-MG Binding with MPO
3.3. Effects of HSA-MG on Enzymatic Activity of MPO
3.4. Effects of HSA-MG on Activation of Neutrophils
3.5. Effects of HSA-MG on Degranulation of Neutrophils
3.6. Effects of HSA-MG on NETosis
4. Discussion
5. Conclusions
Supplementary Materials
Author Contributions
Funding
Institutional Review Board Statement
Informed Consent Statement
Data Availability Statement
Conflicts of Interest
References
- John, W.G.; Lamb, E.J. The Maillard or browning reaction in diabetes. Eye 1993, 7, 230–237. [Google Scholar] [CrossRef] [PubMed] [Green Version]
- Singh, K.; Barden, A.; Mori, T.; Beilin, L. Advanced glycation end-products: A review. Diabetologia 2001, 44, 129–146. [Google Scholar] [CrossRef] [PubMed] [Green Version]
- Angeloni, C.; Zambonin, L.; Hrelia, S. Role of methylglyoxal in Alzheimer’s disease. Biomed. Res. Int. 2014, 2014, 238485. [Google Scholar] [CrossRef] [PubMed] [Green Version]
- Fritz, G. RAGE: A single receptor fits multiple ligands. Trends Biochem. Sci. 2011, 36, 625–632. [Google Scholar] [CrossRef] [PubMed]
- Ott, C.; Jacobs, K.; Haucke, E.; Santos, A.N.; Grune, T.; Simm, A. Role of advanced glycation end products in cellular signaling. Redox Biol. 2014, 2, 411–429. [Google Scholar] [CrossRef] [Green Version]
- Collison, K.S.; Parhar, R.S.; Saleh, S.S.; Meyer, B.F.; Kwaasi, A.A.; Hammami, M.M.; Schmidt, A.M.; Stern, D.M.; Al-Mohanna, F.A. RAGE-mediated neutrophil dysfunction is evoked by advanced glycation end products (AGEs). J. Leukoc. Biol. 2002, 71, 433–444. [Google Scholar] [CrossRef]
- Klebanoff, S.J. Myeloperoxidase: Friend and foe. J. Leukoc. Biol. 2005, 77, 598–625. [Google Scholar] [CrossRef] [Green Version]
- Lu, H.; Xu, S.; Liang, X.; Dai, Y.; Huang, Z.; Ren, Y.; Lin, J.; Liu, X. Advanced glycated gnd products alter neutrophil effect on regulation of CD4+ T cell differentiation through induction of myeloperoxidase and neutrophil elastase activities. Inflammation 2019, 42, 559–571. [Google Scholar] [CrossRef]
- Ahmed, A.; Shamsi, A.; Khan, M.S.; Husain, F.M.; Bilqees, B. Methylglyoxal induced glycation and aggregation of human serum albumin: Biochemical and biophysical approach. Int. J. Biol. Macromol. 2018, 113, 269–276. [Google Scholar] [CrossRef]
- Vakhrusheva, T.V.; Sokolov, A.V.; Kostevich, V.A.; Vasilyev, V.B.; Panasenko, O.M. Enzymatic and bactericidal activity of monomeric and dimeric forms of myeloperoxidase. Biochem. Mosc. Suppl. Ser. B 2018, 12, 258–265. [Google Scholar] [CrossRef]
- Churashova, I.A.; Sokolov, A.V.; Kostevich, V.A.; Gorbunov, N.P.; Runova, O.L.; Firova, E.M.; Vasilyev, V.B. Myeloperoxidase/high-density lipoprotein cholesterol ratio in patients with arterial hypertension and chronic coronary heart disease. Med. Acad. J. 2021, 21, 75–86. [Google Scholar] [CrossRef]
- Sokolov, A.V.; Zakharova, E.T.; Shavlovskiĭ, M.M.; Vasil’ev, V.B. Isolation of stable human ceruloplasmin and its interaction with salmon protamine. Bioorg. Khim. 2005, 31, 269–279. [Google Scholar] [CrossRef]
- Sokolov, A.V.; Kostevich, V.A.; Kozlov, S.O.; Donskyi, I.S.; Vlasova, I.I.; Rudenko, A.O.; Zakharova, E.T.; Vasilyev, V.B.; Panasenko, O.M. Kinetic method for assaying the halogenating activity of myeloperoxidase based on reaction of celestine blue B with taurine halogenamines. Free Radic. Res. 2015, 46, 777–789. [Google Scholar] [CrossRef]
- Gorudko, I.V.; Tcherkalina, O.S.; Sokolov, A.V.; Pulina, M.O.; Zakharova, E.T.; Vasilyev, V.B.; Cherenkevich, S.N.; Panasenko, O.M. New approaches to the measurement of the concentration and peroxidase activity of myeloperoxidase in human blood plasma. Russ. J. Bioorg. Chem. 2009, 35, 566–575. [Google Scholar] [CrossRef]
- Basyreva, L.Y.; Vakhrusheva, T.V.; Letkeman, Z.V.; Maximov, D.I.; Fedorova, E.A.; Panasenko, O.M.; Ostrovsky, E.M.; Gusev, S.A. Effect of vitamin D3 in combination with omega-3 polyunsaturated fatty acids on NETosis in type 2 diabetes mellitus patients. Oxid. Med. Cell. Longev. 2021, 2021, 8089696. [Google Scholar] [CrossRef]
- Tiruppathi, C.; Naqvi, T.; Wu, Y.; Vogel, S.M.; Minshall, R.D.; Malik, A.B. Albumin mediates the transcytosis of myeloperoxidase by means of caveolae in endothelial cells. Proc. Natl. Acad. Sci. USA 2004, 101, 7699–7704. [Google Scholar] [CrossRef] [Green Version]
- Mócsai, A.; Jakus, Z.; Vántus, T.; Berton, G.; Lowell, C.A.; Ligeti, E. Kinase pathways in chemoattractant-induced degranulation of neutrophils: The role of p38 mitogen-activated protein kinase activated by Src family kinases. J. Immunol. 2000, 164, 4321–4331. [Google Scholar] [CrossRef] [Green Version]
- Kasper, B.; Brandt, E.; Bulfone-Paus, S.; Petersen, F. Platelet factor 4 (PF-4)-induced neutrophil adhesion is controlled by src-kinases, whereas PF-4-mediated exocytosis requires the additional activation of p38 MAP kinase and phosphatidylinositol 3-kinase. Blood 2004, 103, 1602–1610. [Google Scholar] [CrossRef]
- Nøorgaard, A.; Andersen, L.P.; Nielsen, H. Neutrophil degranulation by Helicobacter pylori proteins. Gut 1995, 36, 354–357. [Google Scholar] [CrossRef] [Green Version]
- Byun, J.; Mueller, D.M.; Fabjan, J.S.; Heinecke, J.W. Nitrogen dioxide radical generated by the myeloperoxidase-hydrogen peroxide-nitrite system promotes lipid peroxidation of low density lipoprotein. FEBS Lett. 1999, 455, 243–246. [Google Scholar] [CrossRef]
- Björnsdottir, H.; Welin, A.; Michaëlsson, E.; Osla, V.; Berg, S.; Christenson, K.; Sundqvist, M.; Dahlgren, C.; Karlsson, A.; Bylund, J. Neutrophil NET formation is regulated from the inside by myeloperoxidase-processed reactive oxygen species. Free Rad. Biol. Med. 2015, 89, 1024–1035. [Google Scholar] [CrossRef] [PubMed]
- Panasenko, O.M.; Gorudko, I.V.; Sokolov, A.V. Hypochlorous acid as a precursor of free radicals in living systems. Biochemistry 2013, 78, 1466–1489. [Google Scholar] [CrossRef] [PubMed]
- Schmitt, A.; Schmitt, J.; Münch, G.; Gasic-Milencovic, J. Characterization of advanced glycation end products for biochemical studies: Side chain modifications and fluorescence characteristics. Anal. Biochem. 2005, 338, 201–215. [Google Scholar] [CrossRef] [PubMed]
- Westwood, M.E.; Thornalley, P.J. Molecular characteristics of methylglyoxal-modified bovine and human serum albumins. Comparison with glucose-derived advanced glycation endproduct-modified serum albumins. J. Protein Chem. 1995, 14, 359–372. [Google Scholar] [CrossRef] [PubMed]
- Silván, J.M.; van de Lagemaat, J.; Olano, A.; del Castillo, M.D. Analysis and biological properties of amino acid derivates formed by Maillard reaction in foods. J. Pharm. Biomed. Anal. 2006, 41, 1543–1551. [Google Scholar] [CrossRef] [PubMed]
- Agner, K. Verdoperoxidase: A ferment isolated from neutrophils. Acta Physiol. Scand. 1941, 2 (Suppl. 8), 1–62. [Google Scholar]
- Sokolov, A.V.; Pulina, M.O.; Ageeva, K.V.; Runova, O.L.; Zakharova, E.T.; Vasilyev, V.B. Identification of leukocyte cationic proteins that interact with ceruloplasmin. Biochemistry 2007, 72, 872–877. [Google Scholar] [CrossRef]
- Segelmark, M.; Persson, B.; Hellmark, T.; Wieslander, J. Binding and inhibition of myeloperoxidase (MPO): A major function of ceruloplasmin? Clin. Exp. Immunol. 1997, 108, 167–174. [Google Scholar] [CrossRef]
- Sokolov, A.V.; Ageeva, K.V.; Pulina, M.O.; Cherkalina, O.S.; Samygina, V.R.; Vlasova, I.I.; Panasenko, O.M.; Zakharova, E.T.; Vasilyev, V.B. Ceruloplasmin and myeloperoxidase in complex affect the enzymatic properties of each other. Free Radic. Res. 2008, 42, 989–998. [Google Scholar] [CrossRef]
- Samygina, V.R.; Sokolov, A.V.; Bourenkov, G.; Petoukhov, M.V.; Pulina, M.O.; Zakharova, E.T.; Vasilyev, V.B.; Bartunik, H.; Svergun, D.I. Ceruloplasmin: Macromolecular assemblies with iron-containing acute phase proteins. PLoS ONE 2013, 8, e67145. [Google Scholar] [CrossRef] [Green Version]
- Sokolov, A.V.; Pulina, M.O.; Ageeva, K.V.; Ayrapetov, M.I.; Berlov, M.N.; Volgin, G.N.; Markov, A.G.; Yablonsky, P.K.; Kolodkin, N.I.; Zakharova, E.T.; et al. Interaction of ceruloplasmin, lactoferrin, and myeloperoxidase. Biochemistry 2007, 72, 409–415. [Google Scholar] [CrossRef]
- Zabrodskaya, Y.A.; Egorov, V.V.; Sokolov, A.V.; Shvetsov, A.V.; Gorshkova, Y.E.; Ivankov, O.I.; Kostevich, V.A.; Gorbunov, N.P.; Ramsay, E.S.; Fedorova, N.D.; et al. Caught red handed: Modeling and confirmation of the myeloperoxidase ceruloplasmin alpha-thrombin complex. Biometals 2022, 13, 1–12. [Google Scholar] [CrossRef]
- Wong, R.K.M.; Pettit, A.I.; Davies, J.E.; Ng, L.L. Augmentation of the neutrophil respiratory burst through the action of advanced glycation end products. Diabetes 2002, 51, 2846–2853. [Google Scholar] [CrossRef] [Green Version]
- Wong, R.K.M.; Pettit, A.I.; Quinn, P.A.; Jennings, S.C.; Davies, J.E.; Ng, L.L. Advanced glycation end products stimulate an enhanced neutrophil respiratory burst mediated through the activation of cytosolic phospholipase A2 and generation of arachidonic acid. Circulation 2003, 108, 1858–1864. [Google Scholar] [CrossRef] [Green Version]
- Bansal, S.; Siddarth, M.; Chawla, D.; Banerjee, B.D.; Madhu, S.V.; Tripathi, A.K. Advanced glycation end products enhance reactive oxygen and nitrogen species generation in neutrophils in vitro. Mol. Cell. Biochem. 2012, 361, 289–296. [Google Scholar] [CrossRef]
- Ayilavarapu, S.; Kantarci, A.; Fredman, G.; Turkoglu, O.; Omori, K.; Liu, H.; Iwata, T.; Yagi, M.; Hasturk, H.; van Dyke, T.E. Diabetes-induced oxidative stress is mediated by Ca2+-independent phospholipase A2 in neutrophils. J. Immunol. 2010, 184, 1507–1515. [Google Scholar] [CrossRef] [Green Version]
- Vladimirov, Y.A.; Proskurnina, E.V. Free radicals and cell chemiluminescence. Biochemistry 2009, 74, 1545–1566. [Google Scholar] [CrossRef]
- Li, Y.; Zhu, H.; Kuppusamy, P.; Roubaud, V.; Zweier, J.L.; Trush, M.A. Validation of lucigenin (bis-N-methylacridinium) as a chemilumigenic probe for detecting superoxide anion radical production by enzymatic and cellular systems. J. Biol. Chem. 1998, 273, 2015–2023. [Google Scholar] [CrossRef] [Green Version]
- Afanas’ev, I.B.; Ostrakhovitch, E.A.; Mikhal’chik, E.V.; Korkina, L.G. Direct enzymatic reduction of lucigenin decreases lucigenin-amplified chemiluminescence produced by superoxide ion. Luminescence 2001, 16, 305–307. [Google Scholar] [CrossRef]
- Mikhalchik, E.V.; Ivanov, V.A.; Borodina, I.V.; Pobeguts, O.V.; Smirnov, I.P.; Gorudko, I.V.; Grigorieva, D.V.; Boychenko, O.P.; Moskalets, A.P.; Klinov, D.V.; et al. Neutrophil activation by mineral microparticles coated with methylglyoxal-glycated albumin. Int. J. Mol. Sci. 2022, 23, 7840. [Google Scholar] [CrossRef]
- Brestel, E.P. Co-oxidation of luminol by hypochlorite and hydrogen peroxide implications for neutrophil chemiluminescence. Biochem. Biophys. Res. Commun. 1985, 126, 482–488. [Google Scholar] [CrossRef]
- Panasenko, O.M.; Chekanov, A.V.; Vlasova, I.I.; Sokolov, A.V.; Ageeva, K.V.; Pulina, M.O.; Cherkalina, O.S.; Vasil’ev, V.B. Influence of ceruloplasmin and lactoferrin on the chlorination activity of leukocyte myeloperoxidase assayed by chemiluminescence. Biophysics 2008, 53, 268–272. [Google Scholar] [CrossRef]
- Panasenko, O.M.; Mikhalchik, E.V.; Gorudko, I.V.; Grigorieva, D.V.; Sokolov, A.V.; Kostevich, V.A.; Vasilyev, V.B.; Cherenkevich, S.N. The effects of antioxidants and hypohalous acid scavengers on neutrophil activation by hypochlorous acid-modified low-density lipoproteins. Biophysics 2016, 61, 420–428. [Google Scholar] [CrossRef]
- Mikhalchik, E.V.; Smolina, N.V.; Astamirova, T.S.; Gorudko, I.V.; Grigorieva, D.V.; Ivanov, V.A.; Sokolov, A.V.; Kostevich, V.A.; Cherenkevich, S.N.; Panasenko, O.M. Human serum albumin modified under oxidative/halogenative stress enhances luminal-dependent chemiluminescence of human neutrophils. Biophysics 2013, 58, 530–536. [Google Scholar] [CrossRef]
- Gorudko, I.V.; Grigorieva, D.V.; Shamova, E.V.; Kostevich, V.A.; Sokolov, A.V.; Mikhalchik, E.V.; Cherenkevich, S.N.; Arnhold, J.; Panasenko, O.M. Hypohalous acid-modified human serum albumin induces neutrophil NADPH oxidase activation, degranulation, and shape change. Free Radic. Biol. Med. 2014, 68, 326–334. [Google Scholar] [CrossRef]
- Sokolov, A.V.; Kostevich, V.A.; Runova, O.L.; Gorudko, I.V.; Vasilyev, V.B.; Cherenkevich, S.N.; Panasenko, O.M. Proatherogenic modification of LDL by surface-bound myeloperoxidase. Chem. Phys. Lipids 2014, 180, 72–80. [Google Scholar] [CrossRef]
- Mikhalchik, E.V.; Lipatova, V.A.; Basyreva, L.Y.; Panasenko, O.M.; Gusev, S.A.; Sergienko, V.I. Hyperglycemia and some aspecrs of leukocyte activation in vitro. Bull. Exp. Biol. Med. 2021, 170, 748–751. [Google Scholar] [CrossRef]
- Berezin, A. Neutrophil extracellular traps: The core player in vascular complications of diabetes mellitus. Diabetes Metab. Syndr. 2019, 13, 3017–3023. [Google Scholar] [CrossRef]
- Joshi, M.B.; Lad, A.; Prasad, A.S.B.; Balakrishnan, A.; Ramachandra, L.; Satyamoorthy, K. High glucose modulates IL-6 mediated immune homeostasis through impeding neutrophil extracellular trap formation. FEBS Lett. 2013, 587, 2241–2246. [Google Scholar] [CrossRef] [Green Version]
- Parker, H.; Albrett, A.M.; Kettle, A.J.; Winterbourn, C.C. Myeloperoxidase associated with neutrophil extracellular traps is active and mediates bacterial killing in the presence of hydrogen peroxide. J. Leukoc. Biol. 2012, 91, 369–376. [Google Scholar] [CrossRef]
- Arampatzioglou, A.; Papazoglou, D.; Konstantinidis, T.; Chrysanthopoulou, A.; Mitsios, A.; Angelidou, I.; Maroulakou, I.; Ritis, K.; Skendros, P. Clarithromycin enhances the antibacterial activity and wound healing capacity in type 2 diabetes mellitus by increasing LL-37 load on neutrophil extracellular traps. Front. Immunol. 2018, 9, 2064. [Google Scholar] [CrossRef]
- Li, Y.M.; Tan, A.X.; Vlassara, H. Antibacterial activity of lysozyme and lactoferrin is inhibited by binding of advanced glycation-modified proteins to a conserved motif. Nat. Med. 1995, 1, 1057–1061. [Google Scholar] [CrossRef]
- Dalhoff, A. Seventy-five years of research on protein binding. Antimicrob. Agents Chemother. 2018, 62, e01663-17. [Google Scholar] [CrossRef] [Green Version]
- Pacher, P.; Beckman, J.S.; Liaudet, L. Nitric oxide and peroxynitrite in health and disease. Physiol. Rev. 2007, 87, 315–424. [Google Scholar] [CrossRef] [Green Version]
- Cosentino, F.; Hishikawa, K.; Katusic, Z.S.; Luscher, T.F. High glucose increases nitric oxide synthase expression and superoxide anion generation in human aortic endothelial cells. Circulation 1997, 96, 25–28. [Google Scholar] [CrossRef] [PubMed]
- Manda-Handzlik, A.; Bystrzycka, W.; Cieloch, A.; Glodkowska-Mrowka, E.; Jankowska-Steifer, E.; Heropolitanska-Pliszka, E.; Skrobot, A.; Muchowicz, A.; Ciepiela, O.; Wachowska, M.; et al. Nitric oxide and peroxynitrite trigger and enhance release of neutrophil extracellular traps. Cell. Mol. Life Sci. 2020, 77, 3059–3075. [Google Scholar] [CrossRef] [PubMed] [Green Version]
- Misztal, T.; Rusak, T.; Tomasiak, M. Clinically relevant HOCl concentrations reduce clot retraction rate via the inhibition of energy production in platelet mitochondria. Free Radic. Res. 2014, 48, 1443–1453. [Google Scholar] [CrossRef]
- You, Q.; He, D.M.; Shu, G.F.; Cao, B.; Xia, Y.Q.; Xing, Y.; Ni, M.; Chen, J.F.; Shi, S.L.; Gu, H.F.; et al. Increased formation of neutrophil extracellular traps is associated with gut leakage in patients with type 1 but not type 2 diabetes. J. Diabetes 2019, 11, 665–673. [Google Scholar] [CrossRef]
- De Souza Ferreira, C.; Araújo, T.H.; Ângelo, M.L.; Pennacchi, P.C.; Okada, S.S.; de Araújo Paula, F.B.; Migliorini, S.; Rodrigues, M.R. Neutrophil dysfunction induced by hyperglycemia: Modulation of myeloperoxidase activity. Cell Biochem. Funct. 2012, 30, 604–610. [Google Scholar] [CrossRef]
- Senior, P.A.; Marshall, S.M.; Thomas, T.H. Dysregulation of PMN antigen expression in Type 2 diabetes may reflect a generalized defect of exocytosis: Influence of hypertension and microalbuminuria. J. Leukoc. Biol. 1999, 65, 800–807. [Google Scholar] [CrossRef]
- Advani, A.; Marshall, S.M.; Thomas, T.H. Impaired neutrophil actin assembly causes persistent CD11b expression and reduced primary granule exocytosis in Type II diabetes. Diabetologia 2002, 45, 719–727. [Google Scholar] [CrossRef] [PubMed]
- Mastej, K.; Adamiec, R. Neutrophil surface expression of CD11b and CD62L in diabetic microangiopathy. Acta Diabetol. 2008, 45, 183. [Google Scholar] [CrossRef] [PubMed]
- Hand, W.L.; Hand, D.L.; Vasquez, Y. Increased polymorphonuclear leukocyte respiratory burst function in type 2 diabetes. Diabetes Res. Clin. Pract. 2007, 76, 44–50. [Google Scholar] [CrossRef] [PubMed]
- Omori, K.; Ohira, T.; Uchida, Y.; Ayilavarapu, S.D.; Batista, E.L., Jr.; Yagi, M.; Iwata, T.; Liu, H.; Hasturk, H.; Kantarci, A.; et al. Priming of neutrophil oxidative burst in diabetes requires preassembly of the NADPH oxidase. J. Leukoc. Biol. 2008, 84, 292–301. [Google Scholar] [CrossRef]
- Unubol, M.; Yavasoglu, I.; Kacar, F.; Guney, E.; Omurlu, I.K.; Ture, M.; Kadikoylu, G.; Bolaman, Z. Relationship between glycemic control and histochemical myeloperoxidase activity in neutrophils in patients with type 2 diabetes. Diabetol. Metab. Syndr. 2015, 7, 119. [Google Scholar] [CrossRef] [Green Version]
- Shah, S.V.; Wallin, J.D.; Eilen, S.D. Chemiluminescence and superoxide anion production by leukocytes from diabetic patients. J. Clin. Endrocrinol. Metab. 1983, 57, 402–409. [Google Scholar] [CrossRef]
- Sawant, J.K. Biochemical changes in polymorphonuclear leucocytes in diabetic patients. J. Postgrad. Med. 1993, 39, 183–186. Available online: https://pubmed.ncbi.nlm.nih.gov/7996492/ (accessed on 9 November 2022).
- Rosenberg, C.S. Wound healing in the patient with diabetes mellitus. Nurs. Clin. N. Am. 1990, 25, 247–261. Available online: https://pubmed.ncbi.nlm.nih.gov/2179891/ (accessed on 9 November 2022). [CrossRef]
- Mancini, L.; Ruotolo, V. Infection of the diabetic foot. Rays 1997, 22, 544–549. Available online: https://pubmed.ncbi.nlm.nih.gov/9550895/ (accessed on 9 November 2022).

| Mixture | Parameters | Control | HSA | HSA-MG | Ki HSA-MG, μM |
|---|---|---|---|---|---|
| 2–50 μM H2O2 (1 mM ABTS, 5 nM MPO) | KM, µM | 21.3 ± 0.5 | 21.9 ± 0.6 | 21.5 ± 0.5 | 0.84 |
| Vmax, s−1 | 65.1 ± 1.3 | 64.4 ± 1.4 | 21.5 ± 0.5 | ||
| 0.4–2 mM ABTS (50 μM H2O2, 5 nM MPO) | KM, mM | 1.06 ± 0.08 | 1.05 ± 0.09 | 1.04 ± 0.07 | 1.08 |
| Vmax, s−1 | 87.2 ± 1.4 | 86.7 ± 1.5 | 59.7 ± 1.3 | ||
| 5–80 μM H2O2 (150 mM NaCl, 10 nM MPO) | KM, µM | 27.4 ± 1.4 | 26.1 ± 1.5 | 25.4 ± 1.3 | 0.80 |
| Vmax, s−1 | 51.2 ± 1.1 | 49.9 ± 1.2 | 31.5 ± 1.1 | ||
| 25–150 mM NaCl (50 μM H2O2, 10 nM MPO) | KM, mM | 85.7 ± 1.8 | 85.8 ± 1.8 | 85.8 ± 1.7 | 0.94 |
| Vmax, s−1 | 49.6 ± 1.0 | 50.2 ± 1.0 | 32.4 ± 0.9 |
| Effector | Time of Incubation, h | NET-like Structures, % | Leukocytes, Cells per µL |
|---|---|---|---|
| Control | 1 | 7.4 ± 0.9 | 5300 ± 290 |
| 3 | 7.1 ± 0.8 | 5200 ± 290 | |
| 1 mg/mL HSA | 1 | 7.4 ± 0.8 | 5200 ± 290 |
| 3 | 7.8 ± 0.8 | 5000 ± 290 | |
| 0.5 mg/mL HSA-MG | 1 | 8.6 ± 0.8 | 5000 ± 280 |
| 3 | 8.8 ± 0.9 | 4900 ± 260 | |
| 1 mg/mL HSA-MG | 1 | 7.2 ± 0.7 | 5200 ± 300 |
| 3 | 7.4 ± 0.9 | 5200 ± 310 |
| Effector | NET-like Structures, % | Leukocytes, Cells per µL |
|---|---|---|
| Control | 12.8 ± 1.1 | 3900 ± 240 |
| 1 mg/mL HSA | 12.1 ± 1.0 | 4000 ± 250 |
| 0.5 mg/mL HSA-MG | 10.9 ± 1.0 | 4000 ± 280 |
| 1 mg/mL HSA-MG | 11.8 ± 1.0 | 4000 ± 270 |
Publisher’s Note: MDPI stays neutral with regard to jurisdictional claims in published maps and institutional affiliations. |
© 2022 by the authors. Licensee MDPI, Basel, Switzerland. This article is an open access article distributed under the terms and conditions of the Creative Commons Attribution (CC BY) license (https://creativecommons.org/licenses/by/4.0/).
Share and Cite
Panasenko, O.M.; Ivanov, V.A.; Mikhalchik, E.V.; Gorudko, I.V.; Grigorieva, D.V.; Basyreva, L.Y.; Shmeleva, E.V.; Gusev, S.A.; Kostevich, V.A.; Gorbunov, N.P.; et al. Methylglyoxal-Modified Human Serum Albumin Binds to Leukocyte Myeloperoxidase and Inhibits its Enzymatic Activity. Antioxidants 2022, 11, 2263. https://doi.org/10.3390/antiox11112263
Panasenko OM, Ivanov VA, Mikhalchik EV, Gorudko IV, Grigorieva DV, Basyreva LY, Shmeleva EV, Gusev SA, Kostevich VA, Gorbunov NP, et al. Methylglyoxal-Modified Human Serum Albumin Binds to Leukocyte Myeloperoxidase and Inhibits its Enzymatic Activity. Antioxidants. 2022; 11(11):2263. https://doi.org/10.3390/antiox11112263
Chicago/Turabian StylePanasenko, Oleg M., Viktor A. Ivanov, Elena V. Mikhalchik, Irina V. Gorudko, Daria V. Grigorieva, Liliya Yu. Basyreva, Ekaterina V. Shmeleva, Sergey A. Gusev, Valeria A. Kostevich, Nikolay P. Gorbunov, and et al. 2022. "Methylglyoxal-Modified Human Serum Albumin Binds to Leukocyte Myeloperoxidase and Inhibits its Enzymatic Activity" Antioxidants 11, no. 11: 2263. https://doi.org/10.3390/antiox11112263
APA StylePanasenko, O. M., Ivanov, V. A., Mikhalchik, E. V., Gorudko, I. V., Grigorieva, D. V., Basyreva, L. Y., Shmeleva, E. V., Gusev, S. A., Kostevich, V. A., Gorbunov, N. P., & Sokolov, A. V. (2022). Methylglyoxal-Modified Human Serum Albumin Binds to Leukocyte Myeloperoxidase and Inhibits its Enzymatic Activity. Antioxidants, 11(11), 2263. https://doi.org/10.3390/antiox11112263







